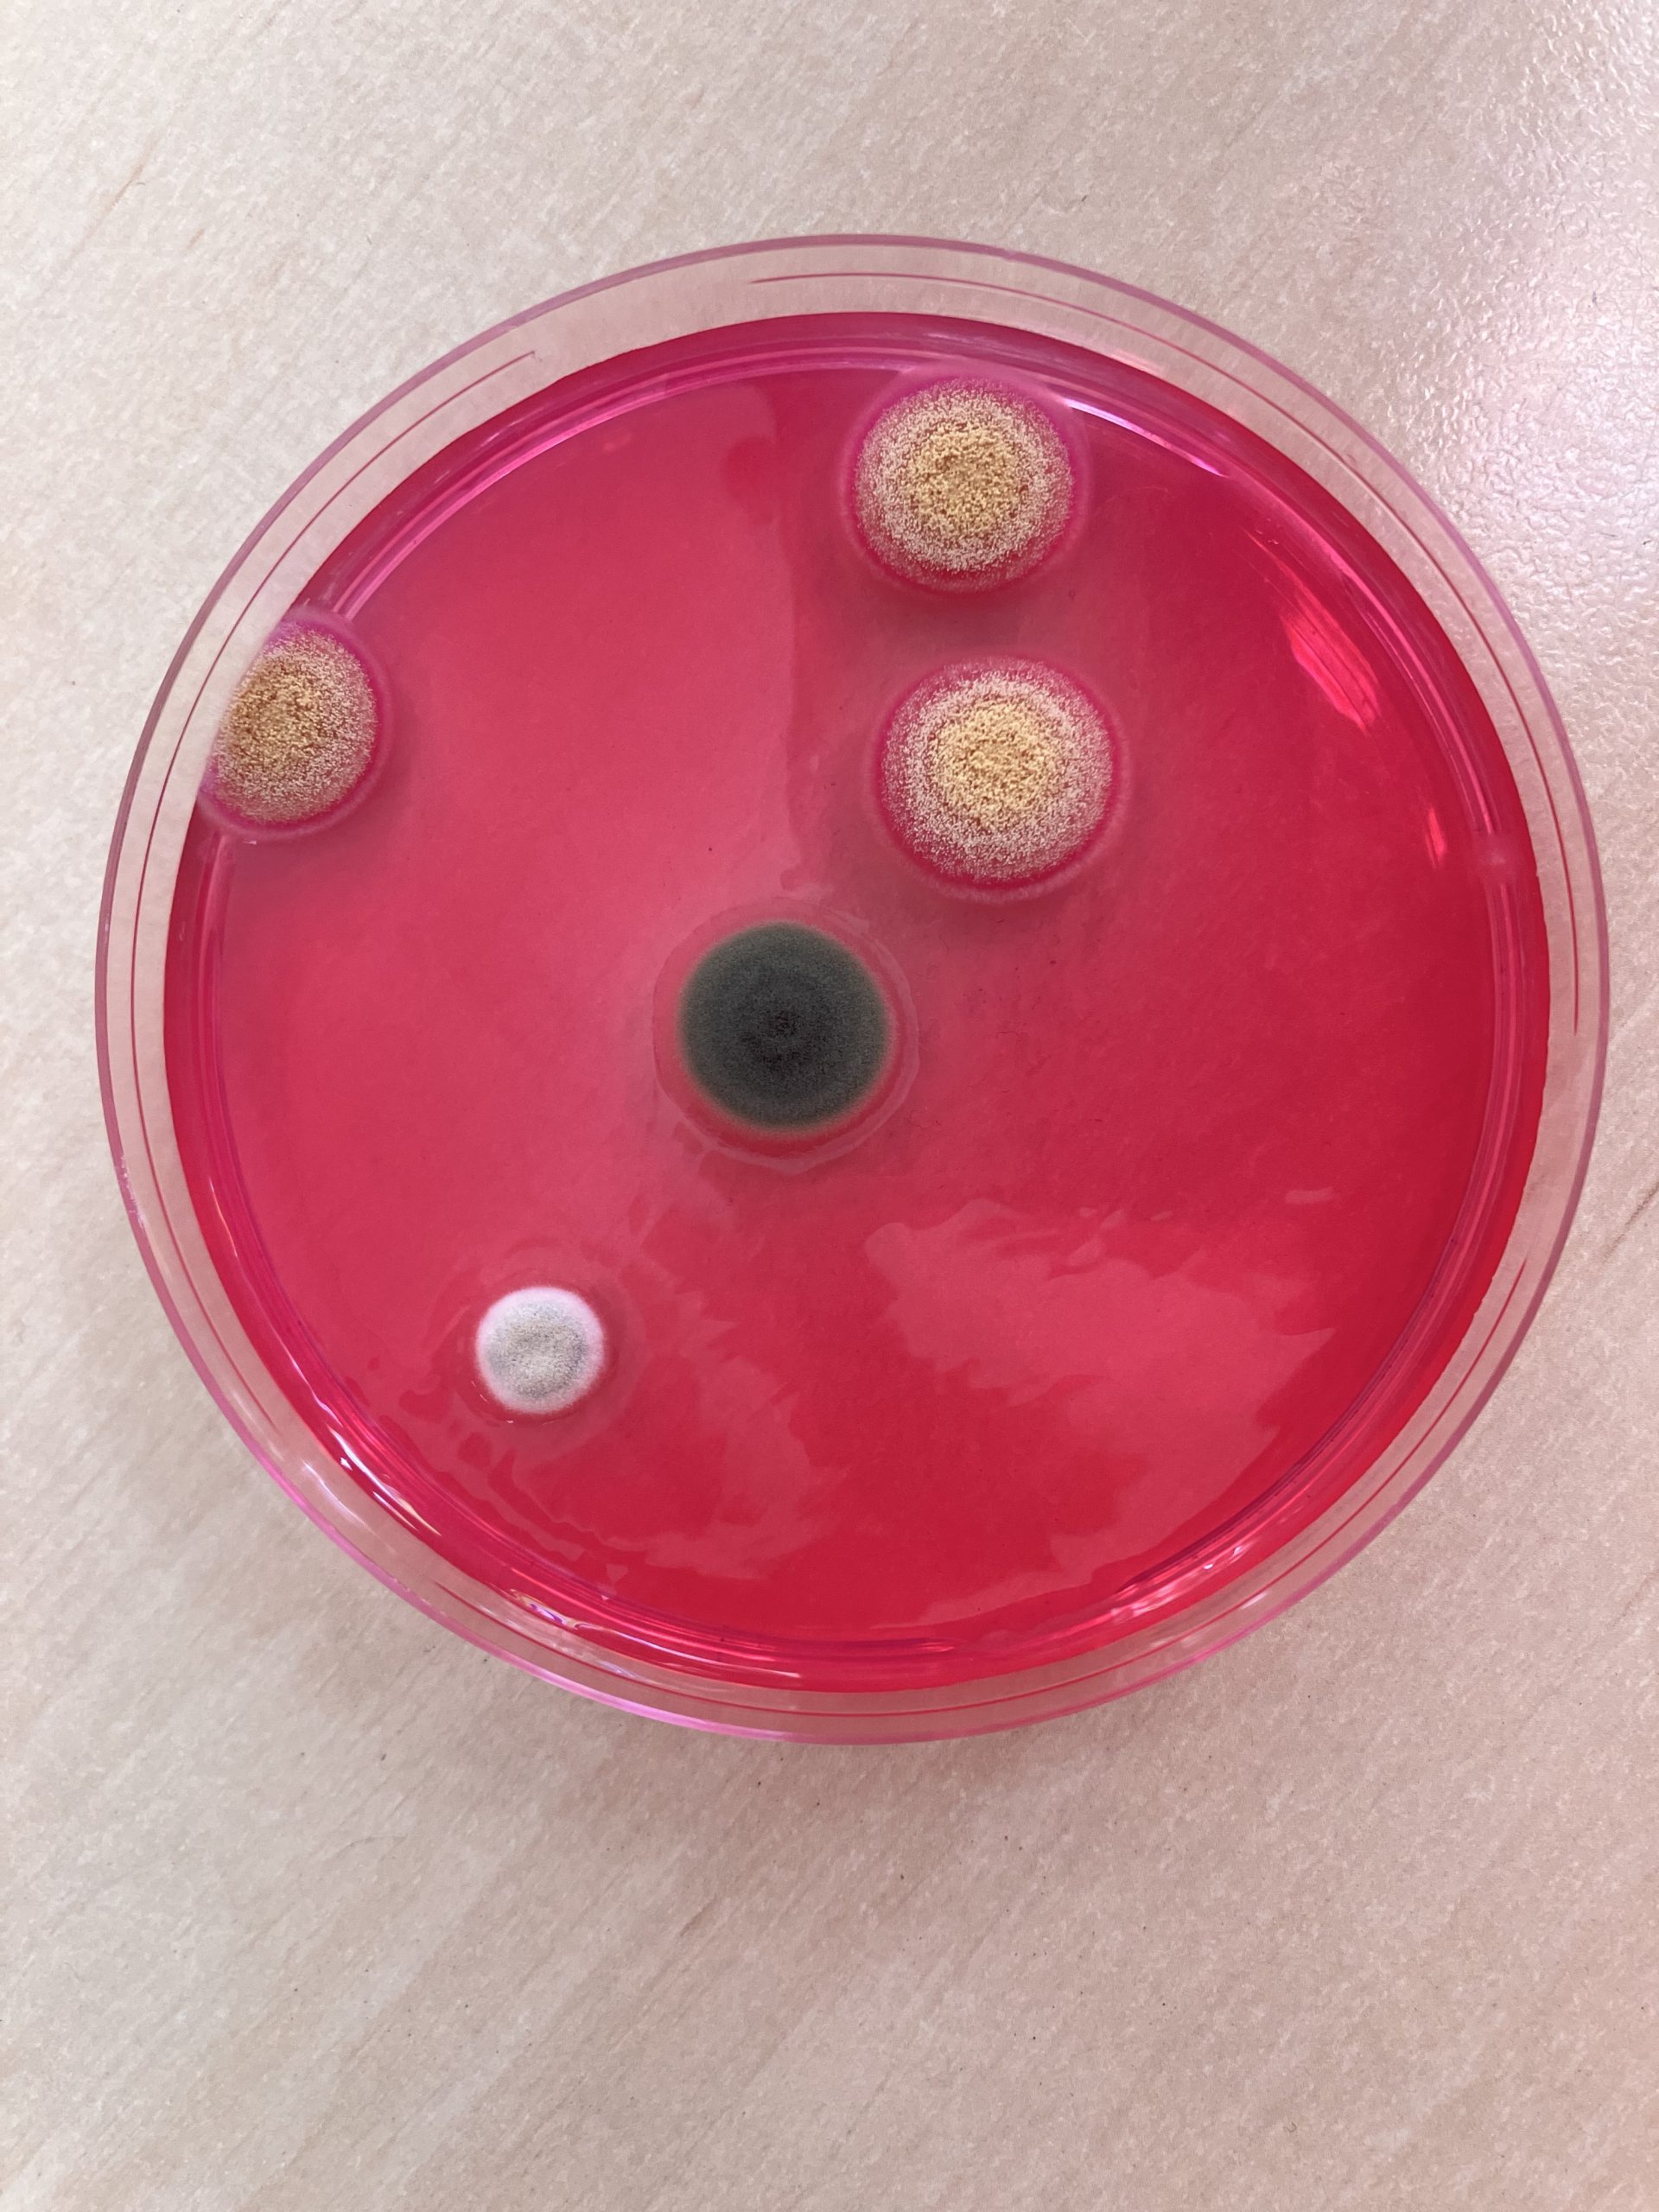
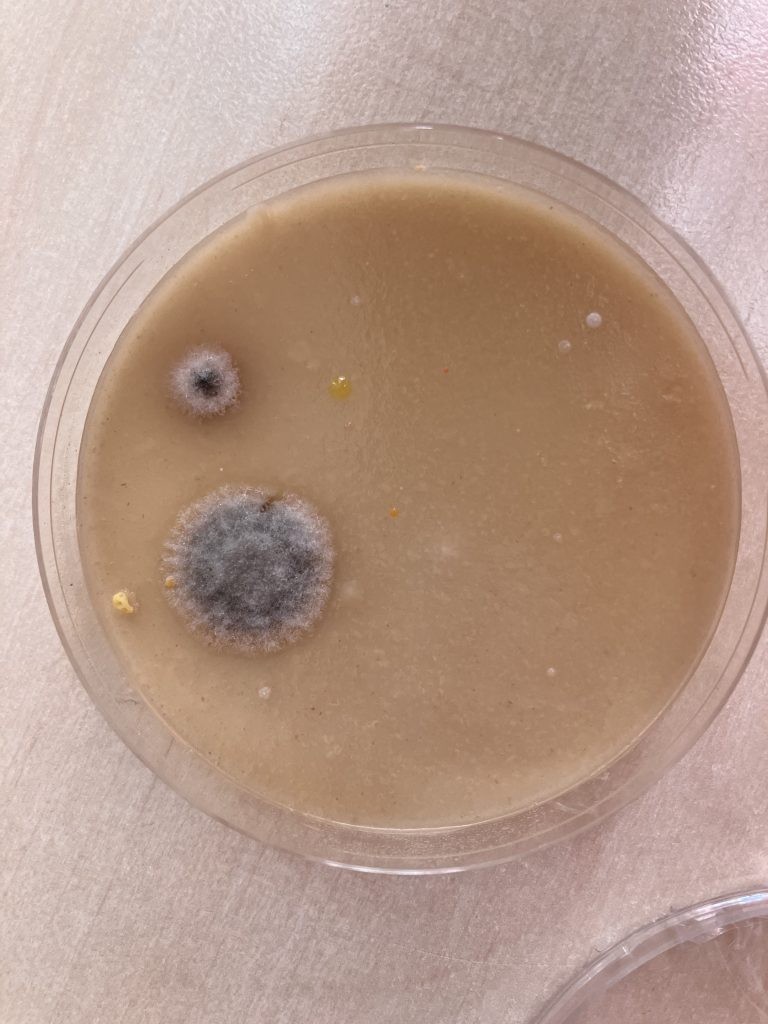
Pestovanie plesní
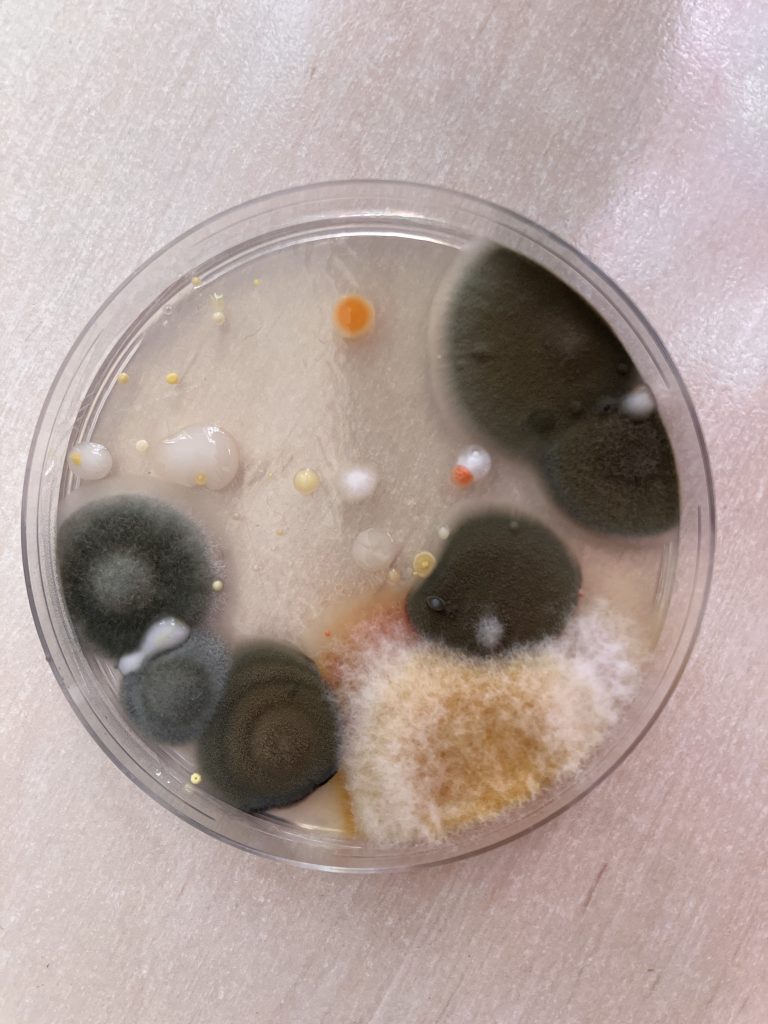
Pestovanie plesní
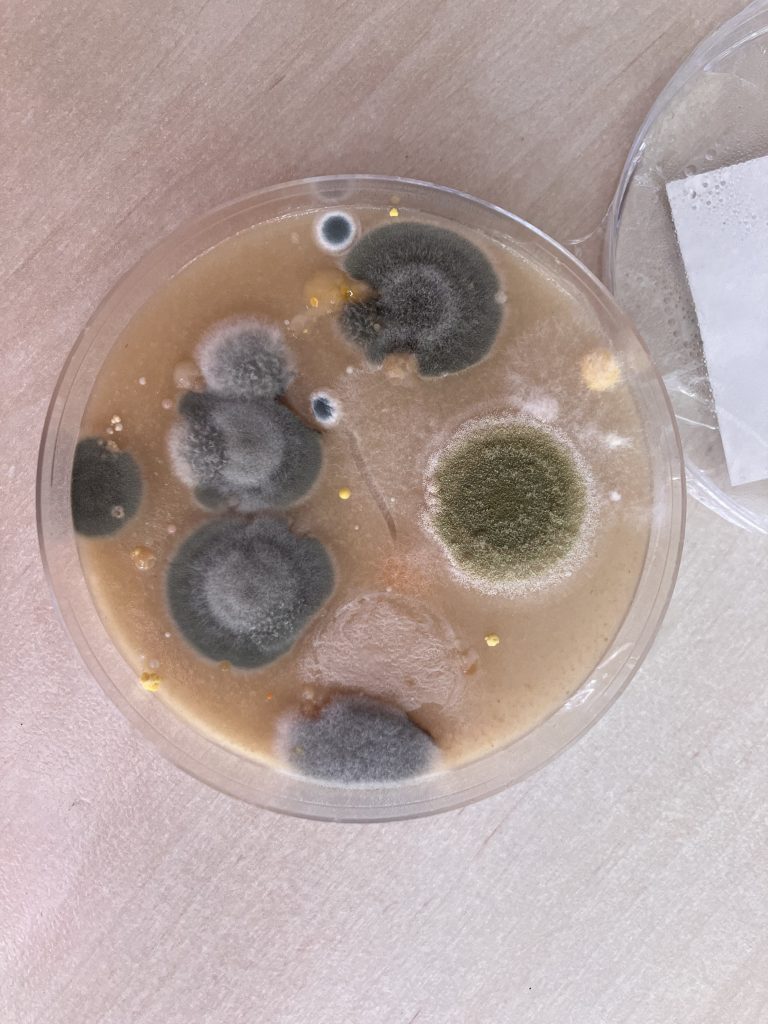
Pestovanie plesní
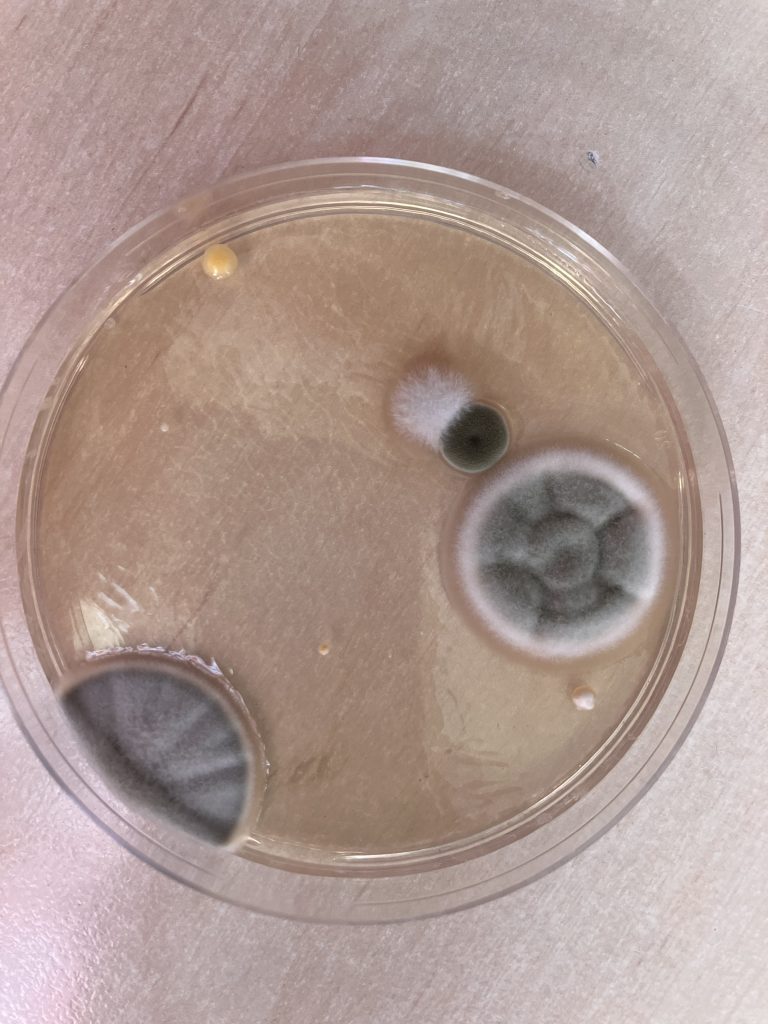
Pestovanie plesní
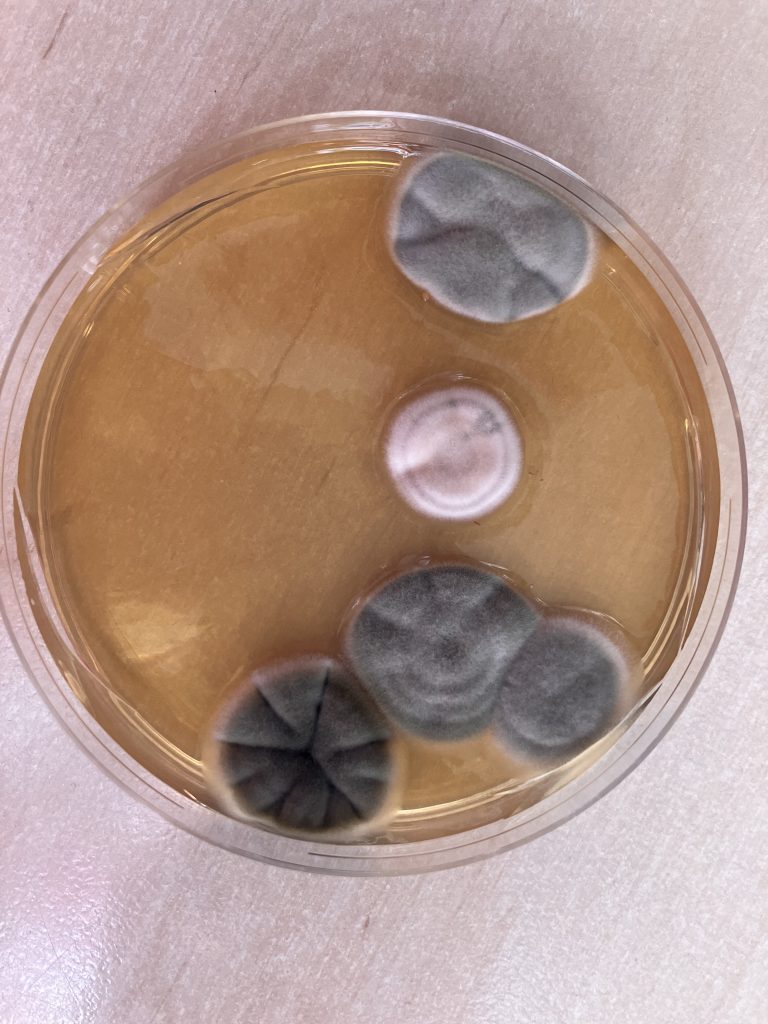
Pestovanie plesní
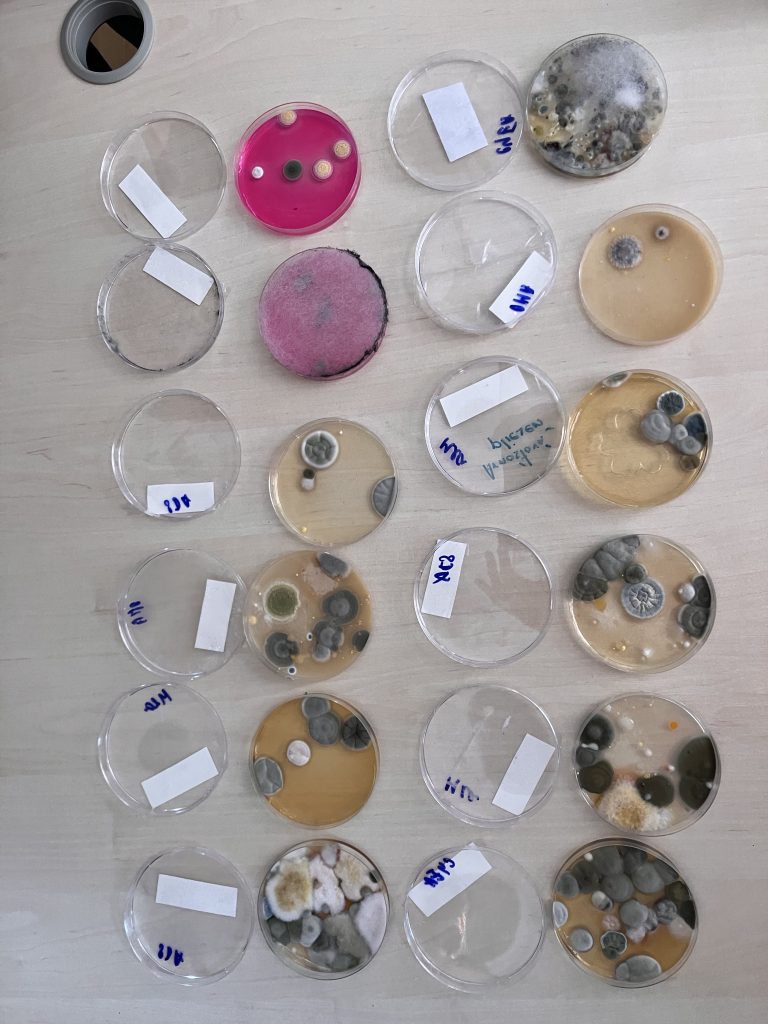
Pestovanie plesní
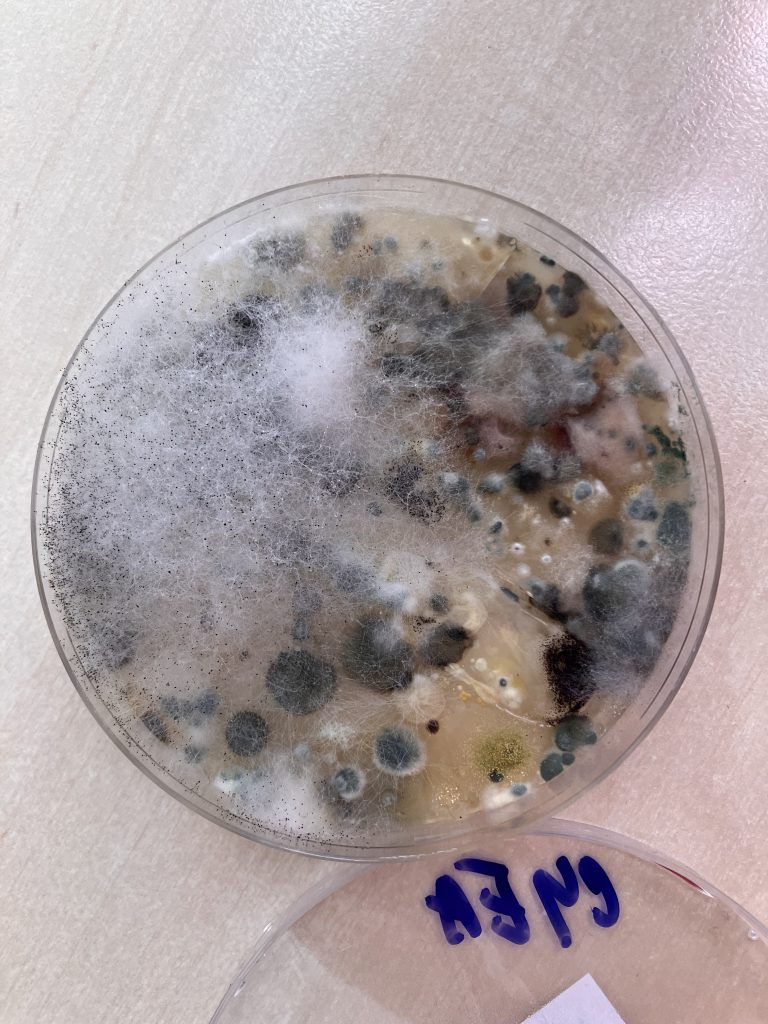
Pestovanie plesní

Štvrtáci sa podujali na netradičný experiment. Pestovali plesne. Najprv kontaktovali pani profesorku z Prírodovedeckej fakulty UK, ktorá sa plesniam venuje, tá im poskytla Petriho misky s agarom, hmotou, v ktorej sa plesne kultivujú, a s návodom ako pleseň vypestovať.
Žiaci si vzali misky domov, kde ich nechali pol hodiny otvorené. Za ten čas všadeprítomné spóry napadali na agar a plesne začali rásť. Po týždni štvrtáci poslali fotografie s plesňami pani profesorke, ktorá ich vyhodnotila. Plesne s bielym okrajom sú z rodu Penicilium, trávovozelené Aspergillus a sivé Cladosporium, prípadne Alternaria. Čierne kolónie sa volajú Cladosporium, ružové pripomínajúce vatu sa nazývajú Fusarium. Biele vlákna s čiernymi hlavičkami sú Rhizopus. I keď sa latinské názvy ťažko zapamätávajú, bol to veľmi zaujímavý experiment, kde sa žiaci naučili, že spóry rôznych mikroorganizmov sa nachádzajú všade. Pani profesorka konštatovala, že plesniam v domácnostiach sa dá zabrániť dostatočným vetraním a dodržiavaním hygienických zásad. Vypestované plesne budú znehodnotené v autokláve, čo je zariadenie na sterilizáciu a zneškodňovanie napríklad takýchto plesní, ktoré by sa ináč šírili ďalej.
Ako pracovať s galériou
Kliknite na fotku pre otvorenie. Vpravo hore nájdete ikonu stiahnutia.
Pri prezeraní kliknite na ikonu fajky alebo stlačte medzerník. Označené fotky sa zobrazia pod galériou.
Pod galériou nájdete tlačidlo na stiahnutie označených fotiek ako ZIP. Tiež ich tam môžete odoslať správcovi s komentárom.